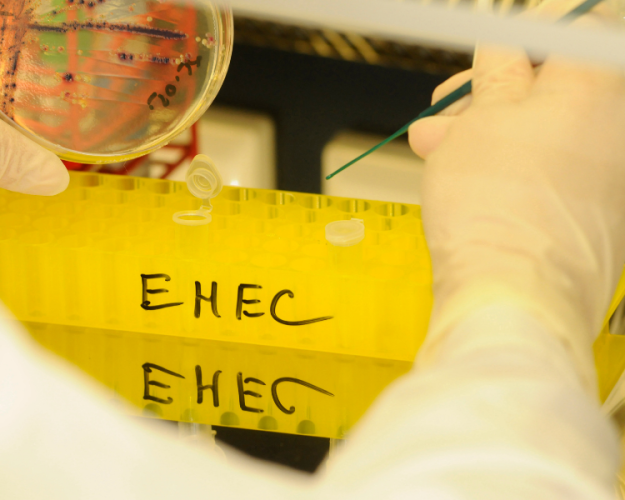

News
Sep 30, 2025 - Foods
Current EHEC Outbreak – What Can Companies Do to Prevent EHEC Infections?
What are EHEC?
EHEC stands for enterohemorrhagic Escherichia coli. These bacteria have the ability to produce strong toxins known as Shiga and verotoxins, and are collectively referred to as STEC/VTEC (Shiga or verotoxin-producing Escherichia coli). The terms STEC and VTEC are used synonymously.
Not all STEC/VTEC cause diseases in humans. Only those STEC/VTEC that are capable of causing severe illnesses in humans are referred to as EHEC.
Occurrence and Routes of Infection:
Escherichia coli bacteria are part of the normal gut flora of humans and animals. The detection of E. coli serves as an indicator of fecal contamination. The intestines of ruminants such as cattle, sheep, and goats, but also deer and elk, are the natural reservoir of enterohemorrhagic Escherichia coli (EHEC), which are excreted with feces. The bacteria can contaminate foods during slaughtering or milking. EHEC is therefore particularly found in raw or insufficiently heated foods such as raw milk, raw milk cheese, raw or undercooked meat and ground meat from ruminants, or spreadable raw sausages (e.g., Mett).
Raw fruits and vegetables grown in or near the ground can also be contaminated with EHEC through contaminated water or cattle manure (e.g., unpasteurized apple juice, raw leafy vegetables like sprouts, spinach, lettuce, ...).
Cross-contamination from contaminated, mostly raw foods to another, mostly ready-to-eat food or indirect transmission through hands, devices, work surfaces, knives, etc., is also possible.
Furthermore, aside from foodborne transmissions, human-to-human transmissions or direct contact with animals (e.g., petting zoos) are important transmission routes. These transmission routes are possible due to the very low infectious dose of <100 CFU (CFU = colony-forming units) (for O157:H7).
Incubation Period, Symptoms, and Risk Groups:
The incubation period, i.e., the time between the ingestion of the pathogen and the appearance of the first symptoms, is on average about 3-4 days. Symptoms range from gastrointestinal complaints with mild diarrhea to severe bloody diarrhea, often associated with abdominal cramps, nausea, vomiting, and fever (hemorrhagic colitis (HC)). On average, about seven days after the onset of diarrhea, HUS diseases associated with EHEC (HUS: hemolytic-uremic syndrome) can occur. In HUS, there is damage to the blood vessels, red blood cells, and kidneys. The latter often requires dialysis. Damage to the nervous system and other organs such as the pancreas and heart can occur as complications of HUS.
Children under 5 years, the elderly, and immunocompromised individuals are particularly frequently affected by severe EHEC diseases with bloody diarrhea and HUS.
Significance and Important Measures for Companies
The following measures can prevent possible causes for the occurrence of EHEC in companies:
- Heating to a core temperature of ≥70°C for at least 2 minutes kills EHEC
- Avoid cross-contamination by separating raw and processed foods during storage and use. In this context, regular cleaning and disinfection of work equipment, objects, and surfaces are also important.
- Maintaining good hand and personal hygiene to prevent transmission to food. It is also important to monitor the health of employees, as they can pose a risk as potential EHEC shedders, especially when suffering from gastrointestinal diseases.
Sources:
- https://www.bav-institut.de/de/news/Was-sind-STEC-VTEC-und-EHEC-Ein-Ueberblick-und-deren-Bedeutung-in-Lebensmitteln
- https://www.bav-institut.de/de/faqs/was-ist-ehec-stec-vtec
